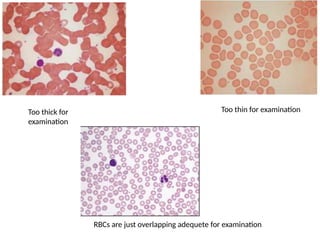
Too thick for
examination
Too thin for examination
RBCs are just overlapping adequete for examination
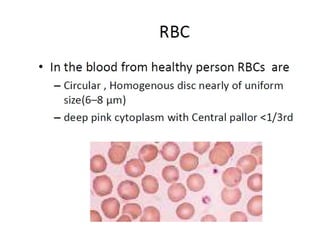
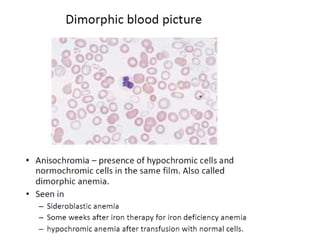
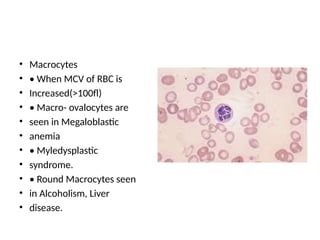
• Macrocytes
• • When MCV of RBC is
• Increased(>100fl)
• • Macro- ovalocytes are
• seen in Megaloblastic
• anemia
• • Myledysplastic
• syndrome.
• • Round Macrocytes seen
• in Alcoholism, Liver
• disease.
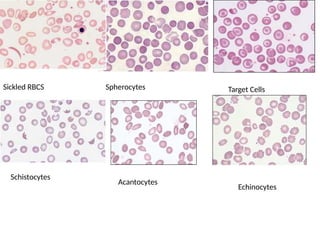
Sickled RBCS Spherocytes Target Cells
Schistocytes
Acantocytes
Echinocytes
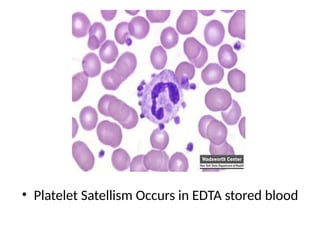
• Platelet Satellism Occurs in EDTA stored blood
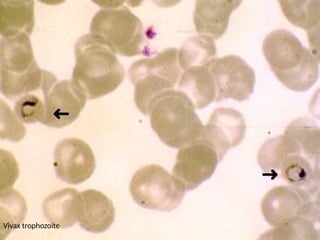
Vivax trophozoite
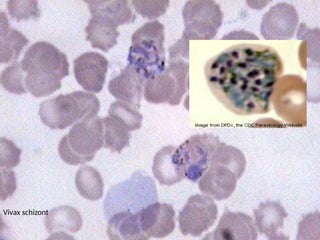
Vivax schizont
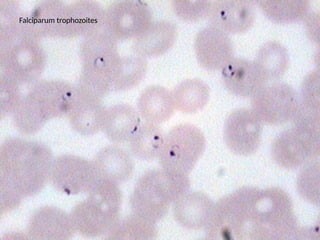
Falciparum trophozoites
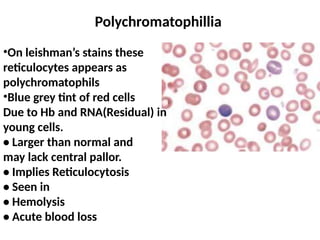
Polychromatophillia
•On leishman’s stains these
reticulocytes appears as
polychromatophils
•Blue grey tint of red cells
Due to Hb and RNA(Residual) in
young cells.
• Larger than normal and
may lack central pallor.
• Implies Reticulocytosis
• Seen in
• Hemolysis
• Acute blood loss

The document outlines basic haematological techniques focusing on peripheral blood smear examination, including specimen collection, slide preparation, staining, and interpretation of blood smears. It details the importance of identifying various conditions through blood films, such as leukocytosis and anemia, alongside the specific microscopic features of blood cells. Techniques for performing and analyzing the smear, as well as the relevant staining methods and interpretations of the results, are thoroughly covered.